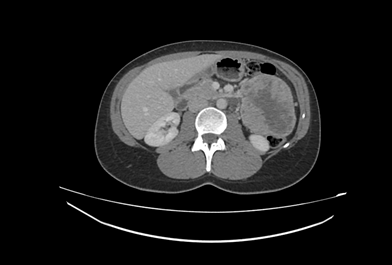

5, 6 y 7 de febrero de 2026
Atención primaria
Mujer de 41 años que consulta por dolor epigástrico siempre pospandrial, de características cólicas que irradia a zona dorsal y a flanco izquierdo de un mes de evolución y además explica tumoración palpable en este nivel.
Enfoque individual
Antecedentes personales sin interés.
En la exploración abdominal se palpa masa bien delimitada en flanco izquierdo en la bipedestación y con maniobras de Valsalva de unos 5 cm de diámetro aproximadamente.
Hallazgos ecográficos
Se completa la exploración en la consulta de Atención Primaria, con ecografía a pie de cama donde se visualiza una imagen de ecoestructura heterogénea, con zonas hiperecoicas y zonas anecoicas, yuxtarrenal izquierda y que capta Doppler en algunas zonas.
Ante la sospecha de tumor gastrointestinal se solicita TAC abdominal urgente.
Pruebas complementarias
TAC abdominal: masa en flanco izquierdo de 8,8 cm que parece depender de la cuarta porción duodenal y plantea como primer diagnóstico diferencial un GIST.
Esofagogastroduodenoscopia: protuberancia duodenal con mucosa preservada de unos 5 cm compatible con lesión submucosa descrita en la prueba de imagen.
Biopsia: fragmento de tumor estromal de tipo fusocelular.
Estudio inmunohistoquímico: expresión fuerte y difusa de C-KIT (CD117) (Clona EP10; Ventana-Roche) y DOG-1 (Clona SP31; Ventana-Roche) a nivel de las células tumorales.
Juicio clínico, diagnóstico diferencial, concordancia con el hospital (en su caso)
El TAC abdominal confirma la sospecha diagnóstica de tumor del estroma gastrointestinal (GIST), se deriva a la paciente a cirugía general con carácter urgente, donde se completa el estudio con una esofagastroduodenoscopia y se presenta el caso en el comité de tumores.
Tratamiento, planes de actuación
Valorado el caso por comité de tumores se decide cirugía inicialmente.
Evolución
Actualmente la paciente está pendiente de la valoración del resultatdo de la biopsia duodenal y estudio immunohistoquímico para valorar necesidad de tratamiento preoperatorio.